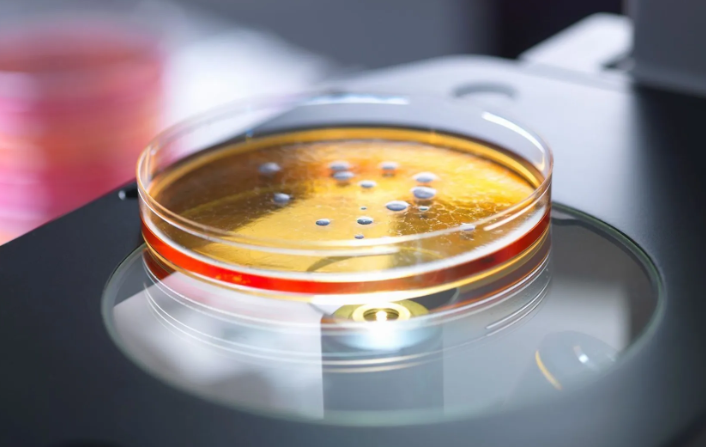

Todo O Mercado Capixaba ganhou com a reestruturação digital da Hubbo Business que ressurge com Força Total
Uma nova era para negócios inteligentes na busca por transformação empreendedora Acesse agora o novo portal hubbo.com.br e descubra como transformar sua visão em realidade com quem entende do jogo. Hubbo Business está de volta – mais ousada, mais integrada e absolutamente preparada para o futuro. O relançamento da sua